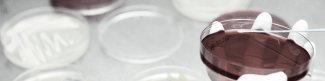
Servicios

Trabalhamos para oferecer serviços que tragam valor acrescentado aos nossos clientes.
Formação para profissionais veterinários
Através da nossa plataforma digital calierformacion.com oferecemos aos profissionais veterinários formação contínua por especialistas reconhecidos em diferentes áreas da saúde animal. O nosso objetivo é estar perto dos especialistas e ajudá-los a manter-se atualizados sobre os últimos desenvolvimentos e tendências no setor da saúde animal.
Consulte os próximos eventos disponíveis em calierformacion.com.


Centro de Diagnóstico da Calier
No nosso Centro de Diagnóstico oferecemos aos nossos clientes um serviço de análise de amostras para identificar organismos causadores de diferentes patologias em animais de produção. Além disso, um serviço de PCR em tempo real para o diagnóstico molecular da salmonela para poder determinar, em tempo recorde, a presença da estirpe que faz parte da vacina Primun Salmonella E nas explorações onde a vacina é utilizada.
Para mais informações, por favor contacte o seu responsável de vendas local.